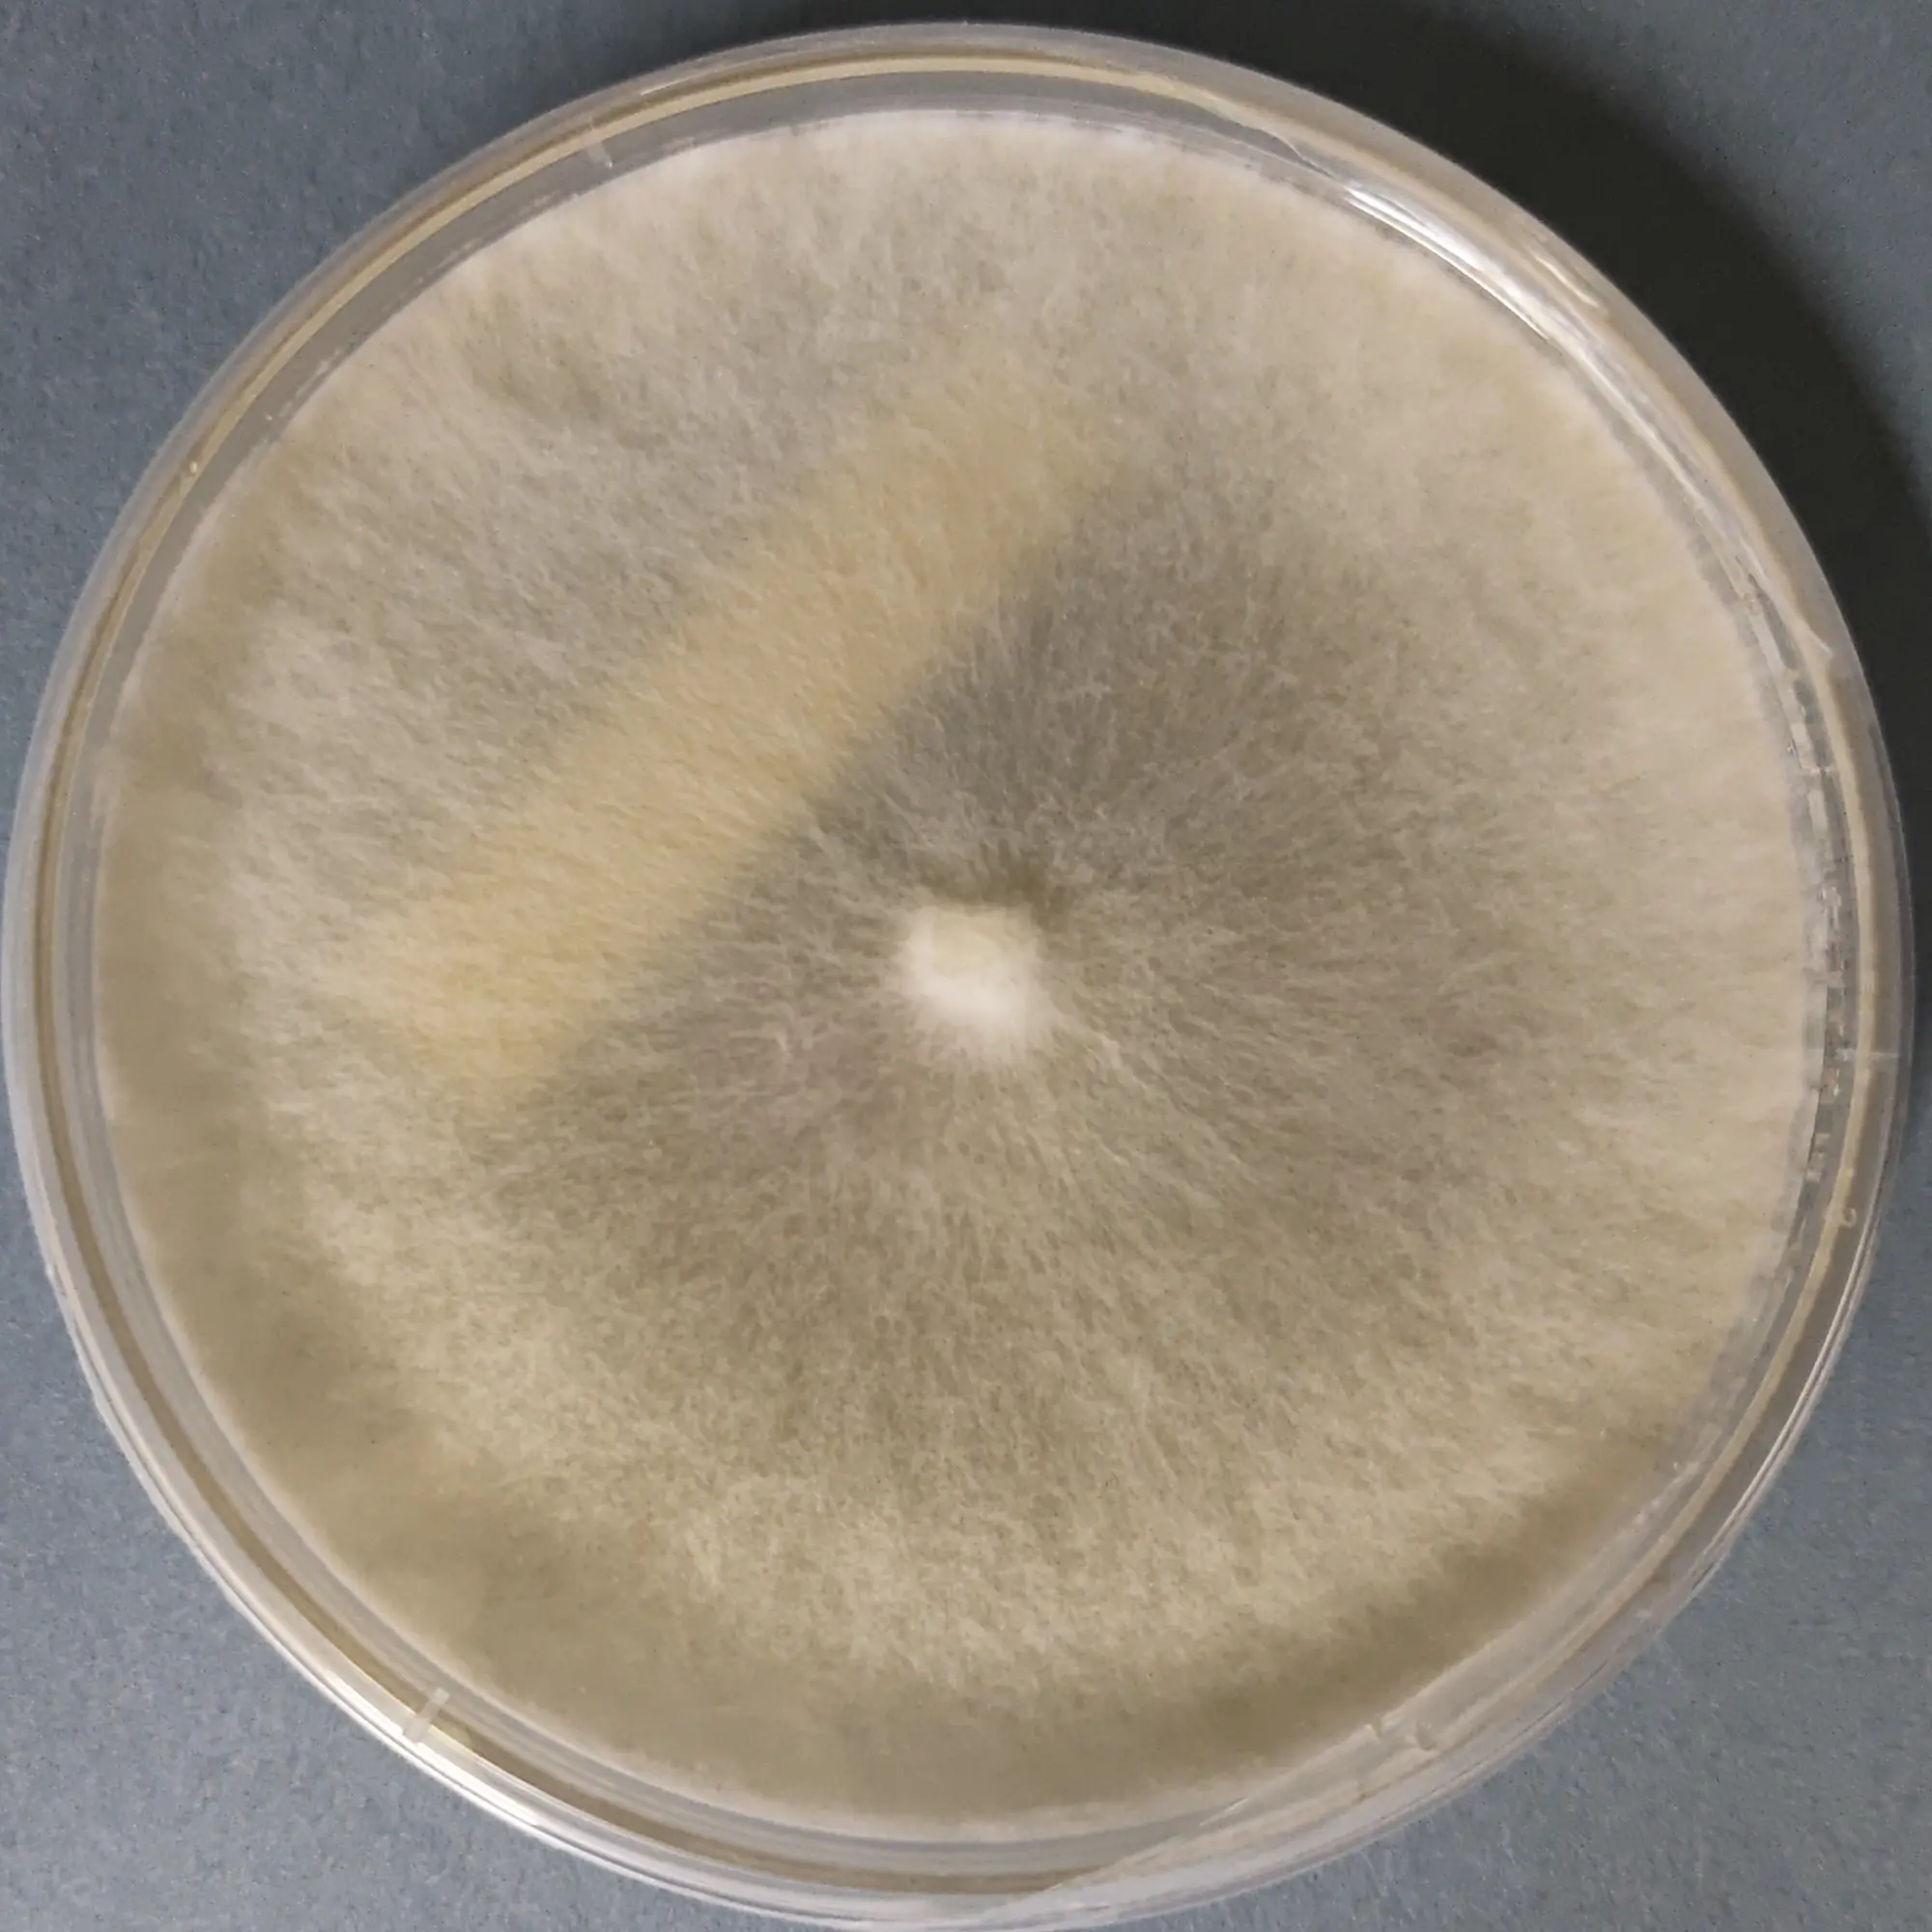
F55 Hypsizygous tessulatus.webp

Poplar Mushroom Culture Plate (Cyclocybe aegerita)
Porcini Mushroom Pure Culture (Boletus edulis)
Poria cocos pure culture plate (Fu ling mushroom)
MUHSROOM CULTURE BANK PURE CULTURE - MEDICINAL MUSHROOMS PURE CULTURE - SPECIALTY MUSHROOMS All Products
Princess Pearl Oyster mushroom Culture (Pleurotus ostreatus)
Purple Morel Culture Plate (Morchella purpurascens)
Reishi Mushroom Culture plate (Ganoderma lucidum)
Sakura Oyster Mushroom Culture (Pleurotus djamor)
Schizophyllum commune culture plate (split gill mushroom)
Shiitake Mushroom Pure Culture Plate (Lentinula edodes)
MUHSROOM CULTURE BANK PURE CULTURE - MEDICINAL MUSHROOMS PURE CULTURE - SPECIALTY MUSHROOMS All Products BESTSELLERS